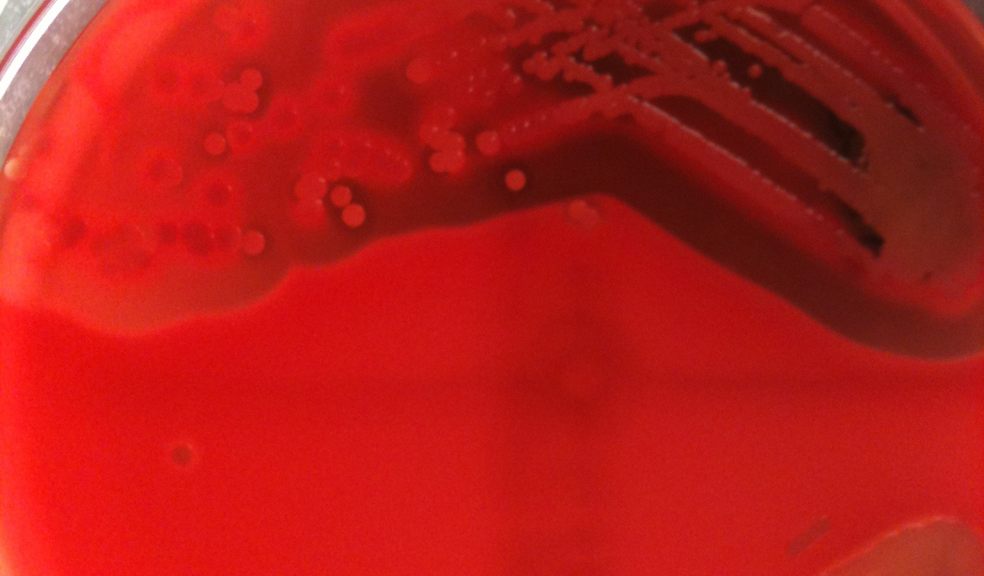

Exeter Scientist's pioneers MRSA predictions
Scientists from universities in the South West have proposed a pioneering technique to help predict the severity of MRSA infection, which could lead to more personalised treatment for individual patients.
MRSA or meticillin-resistant staphylococcus aureus, is a type of bacterial infection that is resistant to a number of widely used antibiotics sometimes known as 'superbugs'. This means it can be more difficult to treat than other bacterial infections.
An international collaboration of scientists, including Dr Mario Recker from the University of Exeter, have used genome sequencing to identify the toxicity of specific infections of the antibiotic-resistant pathogen.
Genome sequencing allows scientists to scan and map the relevant section of an organism’s DNA, which contains millions of sections of genetic code. The state-of-the-art technology enables them to search for specific information in a way that was previously impossible.
This breakthrough could prove vital in determining the most effective course of MRSA treatment, by identifying which infections needs more aggressive treatments, or helping pinpoint which patients need closer monitoring for complications.
In addition to examining genomes of other MRSA strains, the scientists are now working to apply their methodology to other bacterial pathogens, such as Streptococcus pneumonia, a leading cause of deaths in infants and children under the age of five.
The innovative research features in a new study, published in leading scientific journal Genome Research.
Dr Recker, Associate Professor in Applied Mathematics, said: “We know that bacterial pathogens, such as MRSA, are so virulent in part because of their ability to damage a host’s tissue.
“By using whole genome sequences we have been able to predict which would be most toxic, and so therefore would be more likely to cause severe disease. Having identified these novel genetic loci will also shed more light upon the complex machinery regulating bacterial virulence.”
Dr Ruth Massey, from the University of Bath and lead author for the research, said that the standard approach to studying MRSA toxicity has been to focus on a single or small number of genes and proteins.
The new study used whole genome sequences from 90 MRSA isolates - or cultures of microorganisms used for study - to identify more than 100 genetic positions associated with toxicity. Despite belonging to the same ST239 clone, the isolates varied greatly in toxicity.
Importantly, the highly toxic isolates shared a common genetic signature. By looking for this signature in the MRSA genome, the researchers were able to predict which isolates were the most toxic and thus more likely to cause severe disease when used to infect mice.
Dr Massey said: “As the cost and speed of genome sequencing decreases, it is becoming increasingly feasible to sequence the genome of an infecting organism.
In a clinical setting, sequencing may be useful for deciding the course of MRSA treatment. For example, a clinician may treat a highly toxic infection more aggressively, including prescribing certain antibiotics known to reduce toxin expression. The patient also may be monitored more closely for complications and isolated from others to help control the spread of infection.
Although many novel genetic loci involved in MRSA toxicity were identified in this study, it remains to be determined how each influences disease.
Scientists from, Dokuz Eylul University, University of Nottingham, University of Nebraska Medical Center, University of Cambridge, Wellcome Trust Sanger Institute, Emory University, and University of Gothenburg also contributed to this study.
This work was supported by funding from the European Commission the BBSRC, and a Royal Society University Research Fellowship.





















